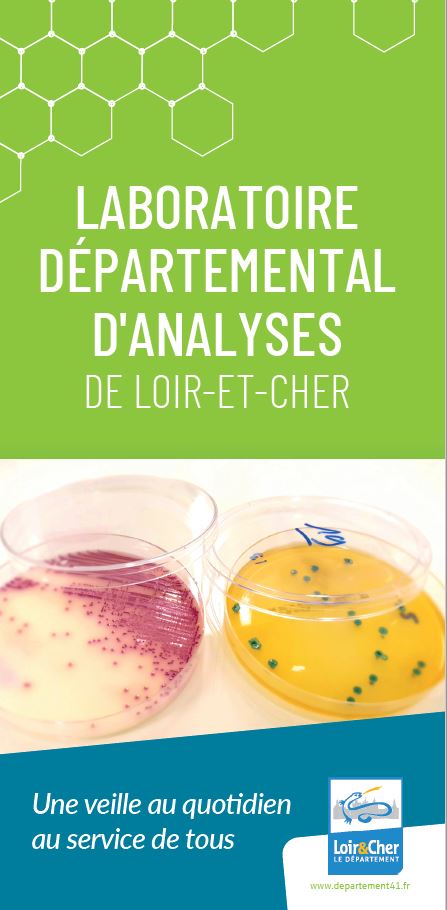

Le Laboratoire départemental d’analyses
-
Plaquette Laboratoire départemental d’analyses
Hygiène alimentaire : un contrôle rigoureux
Le laboratoire veille à la sécurité sanitaire des aliments en réalisant des analyses microbiologiques et des contrôles de surface. Il intervient auprès des collectivités, des artisans et des industriels pour garantir des normes strictes en matière d’hygiène.
Il est notamment chargé de :
- réaliser des contrôles pour les abattoirs et les industries agroalimentaires,
- assurer le suivi microbiologique des repas dans les collèges publics du Loir-et-Cher,
- travailler avec le Groupement de défense sanitaire pour l’analyse des produits laitiers et carnés.
Parasitologie alimentaire : prévenir les risques
Le laboratoire est spécialisé dans la détection des larves de trichines (Trichinella spiralis), un parasite pouvant être présent dans certaines viandes.
- analyses obligatoires pour les viandes issues d’abattoirs (porcs, chevaux, sangliers d’élevage),
- contrôles pour les chasseurs et les ateliers de transformation de gibier (sangliers sauvages).
Contrôles en milieu hospitalier et audits d’hygiène
Le laboratoire intervient également dans les établissements de santé pour :
- vérifier la contamination de l’air et des surfaces,
- accompagner les professionnels via des formations sur l’hygiène et la sécurité alimentaire,
- réaliser des diagnostics hygiénoscopiques dans les cuisines et zones de préparation alimentaire.
Qualité de l’eau : surveiller pour mieux protéger
L’eau est une ressource précieuse qu’il faut contrôler pour garantir sa qualité. Le laboratoire réalise des analyses chimiques et bactériologiques pour tous types d’eaux :
- eaux destinées à la consommation (eaux de réseau, puits, forages),
- eaux sanitaires (prévention du risque légionelles),
- eaux industrielles et de process,
- eaux de loisirs (piscines, plans d’eau),
- eaux issues du milieu agroalimentaire,
- rejets urbains et industriels,
- eaux souterraines et superficielles.
En collaboration avec le service départemental de la qualité de l’eau, le laboratoire analyse également les eaux des stations d’épuration et celles des rivières pour préserver l’environnement.
Un laboratoire accrédité pour garantir la qualité
Le laboratoire est accrédité par le Comité Français d’Accréditation (Accréditation Cofrac essais, N°1-0832, portée disponible sous www.cofrac.fr) pour les analyses dans les domaines des prélèvements et analyses de l’eau, de l’analyse des denrées alimentaires et de la recherche de larves de trichines dans les viandes.
Il dispose également d’agréments pour :
- le contrôle sanitaire des eaux destinées à la consommation humaine,
- l’analyse de l’eau dans le domaine de l’eau et des milieux aquatiques au titre du code de l’environnement,
- la recherche de larves de trichines dans les viandes,
- les analyses de denrées alimentaires.
Ces reconnaissances garantissent un service fiable, reconnu et conforme aux réglementations en vigueur.
-

Environnement: Laboratoire départemental d’analyses
Adresse : 34 avenue du Maréchal Maunoury – porte E 41000 Blois